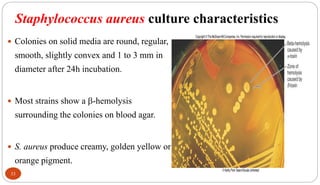
Staphylococcus aureus culture characteristics
33
 Colonies on solid media are round, regular,
smooth, slightly convex and 1 to 3 mm in
diameter after 24h incubation.
 Most strains show a -hemolysis
surrounding the colonies on blood agar.
 S. aureus produce creamy, golden yellow or
orange pigment.
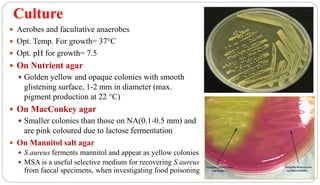
Culture
 Aerobes and facultative anaerobes
 Opt. Temp. For growth= 37°C
 Opt. pH for growth= 7.5
 On Nutrient agar
 Golden yellow and opaque colonies with smooth
glistening surface, 1-2 mm in diameter (max.
pigment production at 22 °C)
 On MacConkey agar
 Smaller colonies than those on NA(0.1-0.5 mm) and
are pink coloured due to lactose fermentation
 On Mannitol salt agar
 S.aureus ferments mannitol and appear as yellow colonies
 MSA is a useful selective medium for recovering S.aureus
from faecal specimens, when investigating food poisoning

Staphylococcus is a genus of bacteria that was first discovered in 1880 by Sir Alexander Ogston. It includes over 40 species that are spherical Gram-positive bacteria that grow in grape-like clusters. The most important human pathogens are S. aureus, S. epidermidis, and S. saprophyticus. S. aureus produces several virulence factors like toxins, enzymes, and surface proteins that allow it to cause a variety of infections in humans like skin infections, pneumonia, sepsis and toxic shock syndrome. Its ability to rapidly evolve antibiotic resistance also makes it an important cause of hospital-acquired infections.